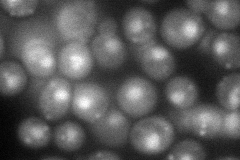
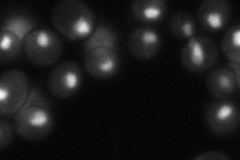

View description
Subunit (17 kDa) of TFIID and SAGA complexes, involved in RNA polymerase II transcription initiation and in chromatin modification, similar to histone H3
Localization:
Intensity:
Fold change:
Significance:
-
C’ GFP library in SD

nucleus60.12 -
N' NOP1pr-GFP in SD

punctate,nucleus79.4035 -
N' TEF2pr-mCherry in SD
punctate,nucleus75.5981 -
N' NATIVEpr-GFP in SD
nucleus66.5451 -
N' TEF2pr-VC and Cyto-VN in SD

#N/A0 -
C’ GFP library in SD+DTT

nucleus69.861.16No -
C’ GFP library in SD+H2O2

nucleus51.520.85No -
C’ GFP library in Starvation Media

nucleus54.990.91No -
C’ GFP library on the background of Pup2-DaMP

nucleus -
C’ GFP library on the background of CCT mutant

nucleus55.80440.928082No
